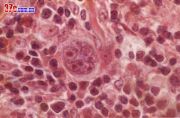

文件列表
来自医学百科
本特殊页面展示所有上传的文件。
| 日期 | 名称 | 缩略图 | 尺寸 | 用户 | 说明 | 版本 |
|---|---|---|---|---|---|---|
| 2014年1月17日 (五) 23:42 | Bkh2i.jpg (文件) |  |
18 KB | Admin | 1 | |
| 2014年1月17日 (五) 23:42 | Bki6f.jpg (文件) |  |
5 KB | Admin | 1 | |
| 2014年1月17日 (五) 23:42 | Bk0b9.jpg (文件) |  |
8 KB | Admin | 1 | |
| 2014年1月17日 (五) 23:42 | Gmonmp7i.jpg (文件) |  |
4 KB | Admin | 1 | |
| 2014年1月17日 (五) 23:42 | Bkqs0.jpg (文件) |  |
13 KB | Admin | 1 | |
| 2014年1月17日 (五) 23:42 | Bkpyw.jpg (文件) |  |
7 KB | Admin | 1 | |
| 2014年1月17日 (五) 23:42 | Bkkog.jpg (文件) |  |
6 KB | Admin | 1 | |
| 2014年1月17日 (五) 23:42 | Bkn59.jpg (文件) |  |
117 KB | Admin | 1 | |
| 2014年1月17日 (五) 23:42 | Gq0p7smo.jpg (文件) |  |
42 KB | Admin | 1 | |
| 2014年1月17日 (五) 23:42 | Bkhrf.jpg (文件) |  |
17 KB | Admin | 1 | |
| 2014年1月17日 (五) 23:42 | Bk3o3.jpg (文件) |  |
29 KB | Admin | 1 | |
| 2014年1月17日 (五) 23:41 | Goqr1e35.jpg (文件) | 3 KB | Admin | 1 | ||
| 2014年1月17日 (五) 23:41 | Bk2wr.jpg (文件) |  |
57 KB | Admin | 1 | |
| 2014年1月17日 (五) 23:41 | Bk4tz.jpg (文件) |  |
257 KB | Admin | 1 | |
| 2014年1月17日 (五) 23:41 | Tutu00007.jpg (文件) |  |
78 KB | Admin | 1 | |
| 2014年1月17日 (五) 23:41 | Gmonn4jp.jpg (文件) |  |
2 KB | Admin | 1 | |
| 2014年1月17日 (五) 23:41 | Bk10m.jpg (文件) |  |
16 KB | Admin | 1 | |
| 2014年1月17日 (五) 23:41 | Bka7b.jpg (文件) |  |
28 KB | Admin | 1 | |
| 2014年1月17日 (五) 23:41 | Bkpxu.jpg (文件) |  |
72 KB | Admin | 1 | |
| 2014年1月17日 (五) 23:41 | Gm7c7lti.jpg (文件) |  |
38 KB | Admin | 1 | |
| 2014年1月17日 (五) 23:41 | Bkkr7.jpg (文件) |  |
113 KB | Admin | 1 | |
| 2014年1月17日 (五) 23:40 | Bk92p.jpg (文件) | |
32 KB | Admin | 1 | |
| 2014年1月17日 (五) 23:40 | Gl0xh2ta.jpg (文件) |  |
17 KB | Admin | 1 | |
| 2014年1月17日 (五) 23:40 | Guwgek7n.jpg (文件) |  |
12 KB | Admin | 1 | |
| 2014年1月17日 (五) 23:40 | Bkfjd.jpg (文件) |  |
19 KB | Admin | 1 | |
| 2014年1月17日 (五) 23:40 | Bk4km.jpg (文件) |  |
9 KB | Admin | 1 | |
| 2014年1月17日 (五) 23:40 | Gmojbg23.jpg (文件) | 5 KB | Admin | 1 | ||
| 2014年1月17日 (五) 23:40 | Bkp3p.jpg (文件) |  |
6 KB | Admin | 1 | |
| 2014年1月17日 (五) 23:39 | Gum5qlwm.jpg (文件) |  |
2 KB | Admin | 1 | |
| 2014年1月17日 (五) 23:39 | Gl98gv5c.jpg (文件) |  |
10 KB | Admin | 1 | |
| 2014年1月17日 (五) 23:39 | Bk5cx.jpg (文件) |  |
50 KB | Admin | 1 | |
| 2014年1月17日 (五) 23:39 | Gunt5rs0.jpg (文件) |  |
23 KB | Admin | 1 | |
| 2014年1月17日 (五) 23:39 | Bkdeb.jpg (文件) |  |
2 KB | Admin | 1 | |
| 2014年1月17日 (五) 23:39 | Bka10.jpg (文件) |  |
31 KB | Admin | 1 | |
| 2014年1月17日 (五) 23:39 | Bk3yv.jpg (文件) |  |
45 KB | Admin | 1 | |
| 2014年1月17日 (五) 23:39 | Gmd6yo6b.jpg (文件) |  |
10 KB | Admin | 1 | |
| 2014年1月17日 (五) 23:39 | Bkk93.jpg (文件) |  |
3 KB | Admin | 1 | |
| 2014年1月17日 (五) 23:39 | Bk401.jpg (文件) |  |
6 KB | Admin | 1 | |
| 2014年1月17日 (五) 23:38 | Glexicqn.jpg (文件) |  |
26 KB | Admin | 1 | |
| 2014年1月17日 (五) 23:38 | Bkodg.jpg (文件) |  |
72 KB | Admin | 1 | |
| 2014年1月17日 (五) 23:38 | Gylanecq.jpg (文件) |  |
34 KB | Admin | 1 | |
| 2014年1月17日 (五) 23:38 | Bkfaq.jpg (文件) |  |
5 KB | Admin | 1 | |
| 2014年1月17日 (五) 23:38 | Gj6zp22m.jpg (文件) |  |
12 KB | Admin | 1 | |
| 2014年1月17日 (五) 23:38 | Bkgdl.jpg (文件) |  |
15 KB | Admin | 1 | |
| 2014年1月17日 (五) 23:38 | Goh89vo9.jpg (文件) |  |
18 KB | Admin | 1 | |
| 2014年1月17日 (五) 23:38 | Bkq4v.jpg (文件) |  |
29 KB | Admin | 1 | |
| 2014年1月17日 (五) 23:38 | Bke8x.jpg (文件) |  |
7 KB | Admin | 1 | |
| 2014年1月17日 (五) 23:38 | Bk1p0.jpg (文件) |  |
31 KB | Admin | 1 | |
| 2014年1月17日 (五) 23:38 | Gl3rjv2l.jpg (文件) |  |
4 KB | Admin | 1 | |
| 2014年1月17日 (五) 23:38 | Bkjhn.jpg (文件) |  |
9 KB | Admin | 1 |